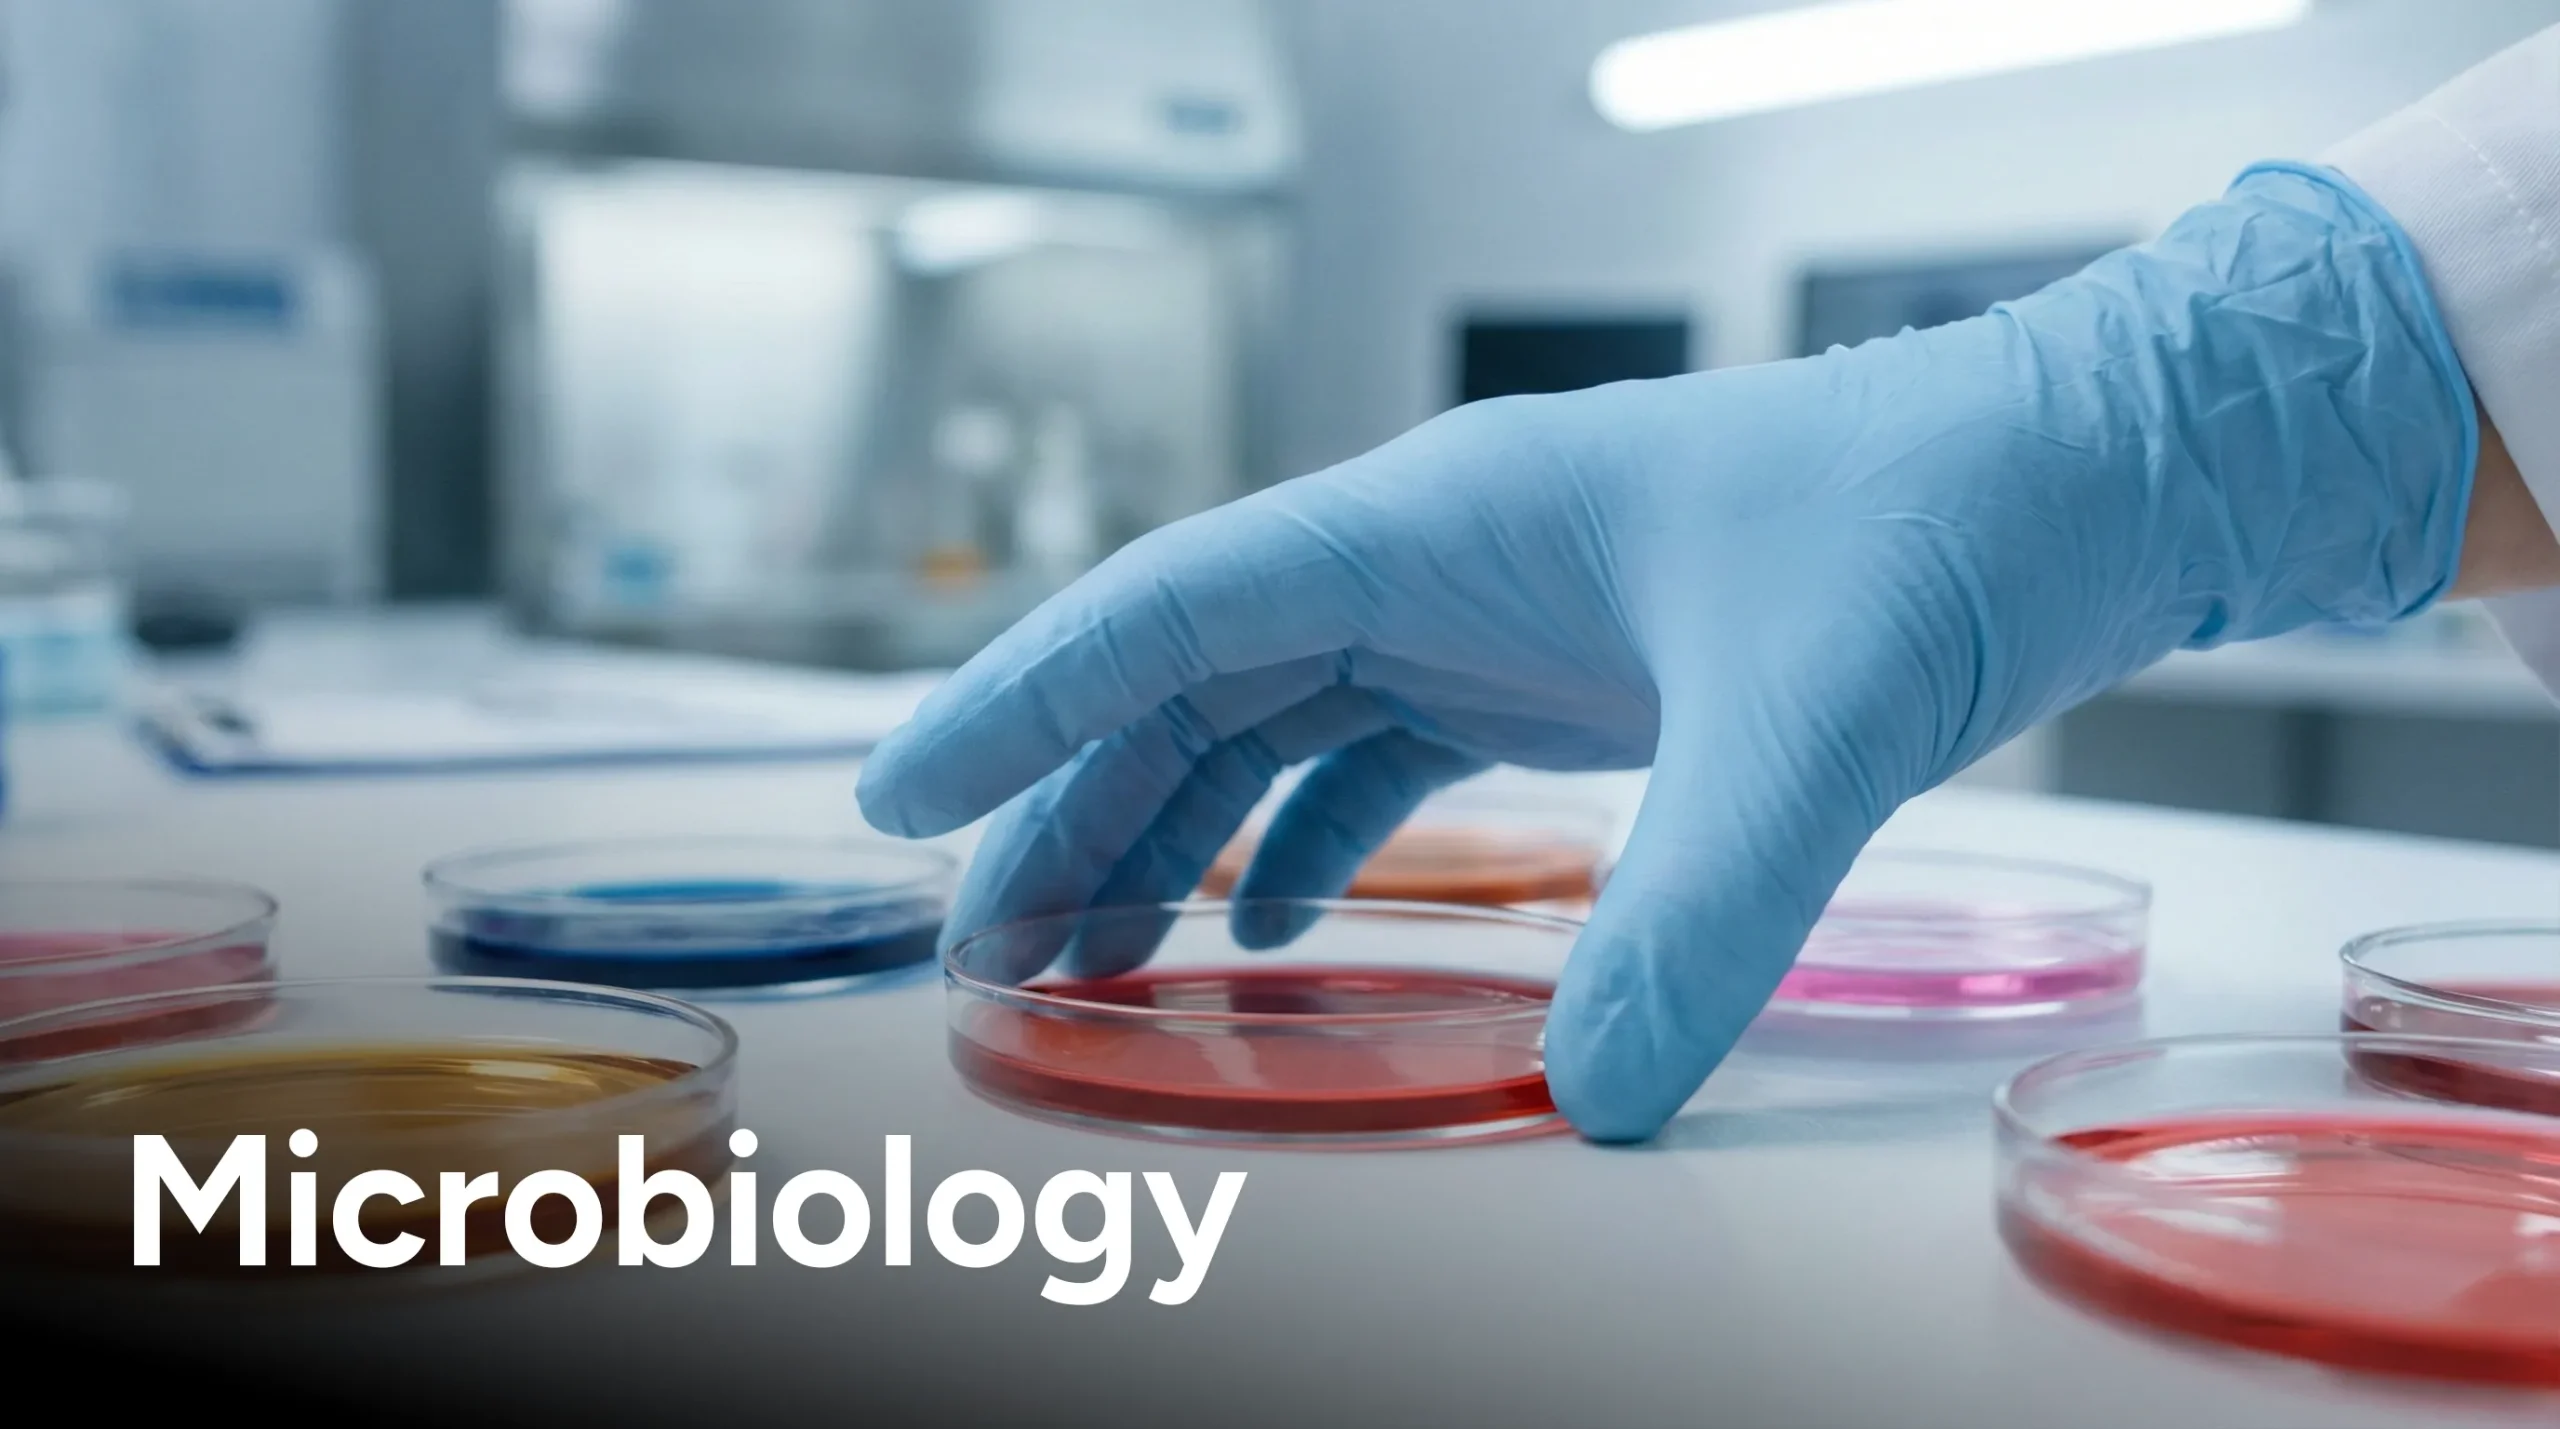

- Home
- About us
- MSR A.1.16
- Academics
- Departments
Pre Clinical



Para Clinical





Clinical













- Student Life
- Achievements
- Research
- Notice & News
- Events
- Career
- Home
- About us
- MSR A.1.16
- Academics
- Departments
Pre Clinical



Para Clinical

Clinical













- Student Life
- Achievements
- Research
- Notice & News
- Events
- Career
"Where Education and Expertise Deliver the Best Healthcare Services"
Welcome to
Jagannath Gupta Institute of Medical Sciences & Hospital – North Kolkata
Excellence in Care and Education
Jagannath Gupta Institute of Medical Sciences & Hospital – North Kolkata (JIMSH-NK) is a modern tertiary care teaching hospital with 450 beds, expanding to 1200, offering advanced technology, patient-centered care, and innovative medical education near Kolkata Airport.
Approved & Affiliated

National Medical
Commission (NMC)

The West Bengal University of Health Sciences (WBUHS)

Our Vision
To become the country's most trusted healthcare organization by: "Achieving excellence in patient care, driving medical innovation, and enhancing education, thereby fostering a healthier and more equitable future for all."
Our Mission
"To provide empathetic, exceptional, and evidence-informed patient care, while nurturing the next generation of medical professionals through a commitment to excellence, integrity, and compassion."
The Legacy
Jagannath Gupta Institute of Medical Sciences & Hospital – North Kolkata draws its strength and inspiration from its parent institution, Jagannath Gupta Institute of Medical Sciences & Hospital – Budge Budge, established in 2016.
Programmes We Offer
Shaping Future Doctors Through Excellence
Programme details
MBBS
Bachelor of Medicine,
Bachelor of Surgery
The programme is approved by the National Medical Commission (NMC) and affiliated with the West Bengal University of Health Sciences (WBUHS), ensuring high academic standards, clinical excellence, and comprehensive medical training.
- Duration: 4½ Years & 1 year Internship
- Annual Intake: 100 (One hundred)

Enroll @ JIMSH-NK
Study at JIMSH-NK to build a successful and rewarding future.
Admission Enquiry

Enroll @ JIMSH-NK
Study at JIMSH-NK to build a successful and rewarding future.

Enroll @ JIMSH-NK
Study at JIMSH-NK to build a successful and rewarding future.

Student Testimonials
Voices of Learning and Experience
Indrajit Dey
MBBS | 2024-2028
This is a sample write-up created for student reference, demonstrating basic structure, clarity of thought, and proper academic writing style.
Indrajit Dey
MBBS | 2024-2028
Mahima Chakraborty
MBBS | 2024-2028
This is a sample write-up created for student reference, demonstrating basic structure, clarity of thought, and proper academic writing style.
Mahima Chakraborty
MBBS | 2024-2028
Sahaj Dutta
MBBS | 2024-2028
This is a sample write-up created for student reference, demonstrating basic structure, clarity of thought, and proper academic writing style.
Sahaj Dutta
MBBS | 2024-2028
Indrajit Dey
MBBS | 2024-2028
This is a sample write-up created for student reference, demonstrating basic structure, clarity of thought, and proper academic writing style.
Indrajit Dey
MBBS | 2024-2028
Life @ JIMSH-NK
Learning Beyond Classrooms
Swami Divyananda Maharaj Program on 26.02.2026
JIMSH-NK Visit | 13.03.25
White Coat Ceremony & Cadaveric Oath Taking Ceremony
Nurses Day Celebration 2025
Saraswati Puja Celebration at college campus 2026
Diwali Rangoli | Portico 1 | 2025
Latest Happenings
Celebrating Learning, Culture, and Community
Notice & News
Latest Updates and Important Announcements

Notice Title
Description will be here...

Notice Title
Short description here...

Notice Title
Short description here...

Notice Title
Short description here...

Notice Title
Short description here...

Notice Title
Short description here...

Notice Title
Short description here...

Notice Title
Short description here...

Notice Title
Details will be here...
What Are You Looking For?
Quick Access to Key Information

How to reach

Departments

Admission Procedure

Submit Enquiry

Eligibility Check

Join JIMSH-NK



